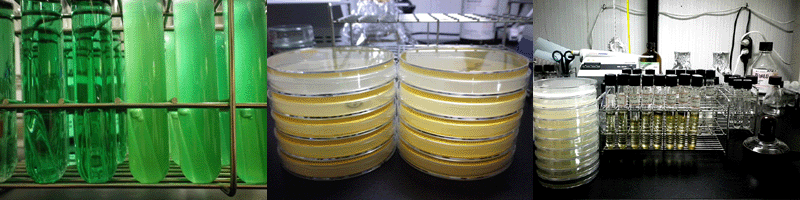

水中の大腸菌群・一般細菌を定量培養するサービスです
●水中の大腸菌群は糞便汚染の指標として、また一般細菌は雑菌数の指標として広く使用されています。
●大腸菌群はBGLB培地によるMPN/100mLとして、一般細菌は標準寒天培地によるCFG/mLとして求めます。
●試験結果は『試験結果報告書』として提出します。
●接種後、36℃で24時間培養し、それぞれの菌数を求めます。必用があれば、速報をメール報告可能です。
分析写真 BGLB培地による大腸菌群の検出(左) 標準寒天培地による一般細菌の検出(中) その他の微生物試験(右)
1.大腸菌群
(1)河川環境指標
●水中の大腸菌群の数を、BGLB培地の反応により、100mL中の最確数(MPN/100mL)で求めます。
●試水を10倍、100倍、1000倍に希釈し、それぞれをBGLB培地の試験管3本に接種します。
●接種後、35℃で24時間培養し、ガス発生の有無で陽性・陰性を判断します。
■100mLの無菌ビンに試料を採取し、冷蔵で搬入してください。一般細菌と併用できます。新たに採取する必要はありません。
□培養条件は、分析対象によって多少異なります。
□その他採取方法等についてはお問い合わせください。
◎1検体当たりの料金は2,000円から設定しております。
(2)食品・飲料水・水道水
●食品(水)中の大腸菌群の数を、BGLB培地の反応により、1g(100mL)中の最確数(MPN/gまたは100mL)で求めます。
●調整試水を10倍、100倍、1000倍に希釈し、それぞれをBGLB培地の試験管3本に接種します。
●接種後、35℃で24時間培養し、ガス発生の有無で陽性・陰性を推定します(推定試験)。
●推定陽性となった試験管試料をEMB寒天培地に画線塗抹し、35℃で24時間培養して定型的集落形成の有無を判定します(確定試験)。
●確定試験陽性となった定型的集落をLB培地に接種し、35℃で24時間培養してガス発生能を判定します(完全試験)。
■100mLの無菌ビンに試料を採取し、冷蔵で搬入してください。一般細菌と併用できます。新たに採取する必要はありません。
□培養条件は、分析対象によって多少異なります。
□その他採取方法等についてはお問い合わせください。
◎1検体当たりの料金は2,500円から設定しております。
2.一般細菌
●食品(水)中の一般細菌の数を、標準寒天培地上に増殖するコロニーの数(CFG/gまたはmL)で求めます。
●調整試水を10倍、100倍、1000倍に希釈し、それぞれを標準寒天培地2枚に接種します。
●接種後、36℃で48時間培養し、標準寒天培地上に増殖するコロニーの数を計数します。
■100mLの無菌ビンに試料を採取し、冷蔵で搬入してください。大腸菌群と併用できます。新たに採取する必要はありません。
□培養条件は、分析対象によって多少異なります。
□その他採取方法等についてはお問い合わせください。
◎1検体当たりの料金は1,500円から設定しております。
3.その他の微生物
●大腸菌群、一般細菌以外の微生物検査として、鉄細菌、真菌類その他の検出、生理試験、殺菌試験等のサービスを行っております。
□その他の微生物試験についてはお問い合わせください。
【お問合せ】
 |
お問合せページへ |
|
|
|
|